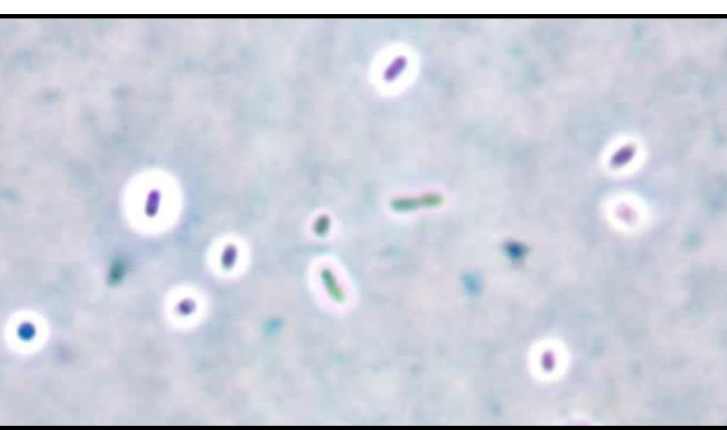

Describe the following colony margins from left to right

circular, irregular, filamentous, rhizoid
Describe the following colony margins from left to right

entire, undulated, lobate, curled, filiform
describe the following elevation patterns from left to right

flat, raised, umbonated
Describe the following elevation patterns from left to right

crateriform, convex, pulvinate
what type of stain is this? What are the blue cells what are the pink/purple cells

Acid fast stain
Blue- non-acid fast
Pink/purple- acid fast
what stain is this and what are the steps
Capsule stain
1. Use India ink, Congo red, nitrgrosin or eosin stain- stain capsules
2. Air dry
3. Flood with crystal violet or methylene blue- will stain cells but not capsules
what stain is this and what are teh steps

Endospore stain
1. air dry and heat fix organism nd cover with blotting paper or towel
2. Saturate blotting paper with malachite green and steam over burner for 5 minutes while keeping paper moist by adding more dye
3. Wash slide in tap water
4. Counter gain with safari in , wash with water and then blot dry
describe the potassium hydroxide test, how to do it, what is happening, what bacteria is most likely if positive
- Add drop of KOH to loop full of bacteria on slide
- KOH interact and degrade peptidoglycan layer producing viscous solution
- If viscous solution occurs most likely gram negative bacteria (thin peptidoglycan layer)
Likely not gram positive due to thick peptidoglycan layer
how does the catalase reaction work, how do you do it, what does it tell you
- Add a drop of 3% hydrogen peroxide and a loop full of bacteria
- If the bacteria has the catalase enzyme bubbling will occur—> positive test
How does the coagulase test work, what do you do, how to interpret results
- transfer 1 colony into a tube with 0.5mL of serum and incubate
- positive result will have coagulated plasma that is unable to be resuspended with shaking
- Negative result will be in liquid state
how does the oxidase test work, what does it tell you
- Place a loop full of bacteria onto oxidase paper
- If it turns purple it contains enzyme- cytochrome C oxidase which is found in many aerobic and facultative bacteria
What test is this

Potassium hydroxide test- positive shows vicious solution- typical of gram negative bacteria
what test is this

Catalase test- bubbling is positive
What test is this

Oxidase test- purple= positive


